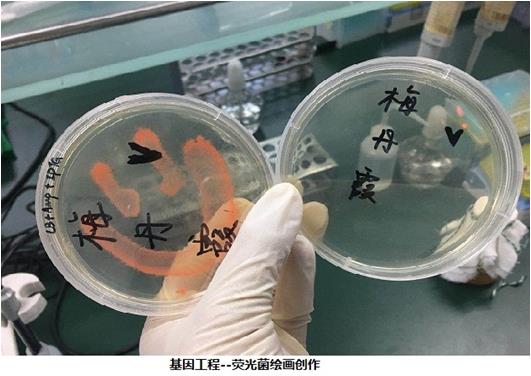

分子平台简介
一、平台和师资情况
分子实验教学平台隶属球盟会QMH(中国)官方网站 基础医学院医学教学实验中心,由生物化学与分子生物学和细胞生物学与医学遗传学两个学系组成,承担《生物化学》、《细胞生物学》、《医学遗传学》实验课程开设。教学对象包括临床医学、药学、护理、口腔等专业本科学生。平台现有生物化学与分子生物学系教授9人,副教授3人,讲师6人;细胞生物学与医学遗传学教授6人、副教授2人、讲师6人;平台现有技术教师3人,其中中级实验师3人。
二、 实验教学课程内容
1. 生物化学与分子生物学实验课程
生物生化与分子生物学是生命科学研究的重要奠基石,也是学生开展基础医学研究的重要启蒙课程。课程设计以让学生加深理解生物化学与分子生物学课程的基本理论,掌握基本实验技能为基本,重在培养学生实验科学思维以及综合分析实验问题的能力,并深化学生对学科前沿的了解。课程内容包括:基本操作与常用技术培训;尿蛋白SDS-PAGE分析;血糖测定;Km值测定;基因工程综合实验;分子生物学常用软件使用及其数据分析等内容。
2. 细胞生物学实验与医学遗传学实验
课程设计旨在使学生掌握细胞生物学和医学遗传学的基本实验方法和技能,锻炼学生的动手能力;训练学生观察、比较、记录、分析、判断、推断等学科思维能力及培养独立工作和实事求是的科学作风。课程内容包括:细胞培养概述;细胞培养的无菌操作;细胞复苏和细胞微丝的染色及形态观察;细胞传代培养、计数、冻存及密度换算;细胞微管蛋白的免疫荧光染色及观察;人类基因组DNA的提取技术;PCR扩增及遗传病基因突变检测等内容。
三、 平台创新特色
1. 尿蛋白浓度测定及蛋白质电泳
蛋白质异常地经尿液排泄是肾脏最为重要的临床病征之一,也是导致多种临床表现的病理生理基础,因此尿蛋白检测是肾脏疾病临床的重要指标。尿蛋白样品从医院收集后,学生通过蛋白电泳方法对尿蛋白样品进行分析,一方面能够让学生掌握生物化学的经典实验方法—蛋白质电泳的基本操作,并对肾病患者尿蛋白组分特征进行分析,培养学生独立分析实验结果的能力及了解设置实验组和空白组的重要性;另外一方面通过这一系列过程,让学生了解临床实验样品的获取应符合医学伦理学规范,将生物化学实验与临床检测有机融合,进一步提高学生的医学素养。
2. 基因工程综合实验
基因工程是以分子遗传学为理论基础,以分子生物学和微生物学的现代方法为手段,将不同来源的基因按预先设计的蓝图,在体外构建重组DNA分子,导入活细胞,以改变生物原有的遗传特性、获得新品种、生产新产品,是基因的结构和功能的研究的重要方法之一。基因工程综合实验是生物化学实验课中最经典有趣的实验课程,在这三次课程当中,学生不仅可以学习到从细菌培养、质粒提取、载体构建、蛋白表达等一系列完整的基因工程操作,同时还在这一过程中增添了多种趣味性的小实验,例如:利用红色荧光菌在平板上作画,让学生练习无菌操作的同时,充分发挥学生的想象力,增添了实验的趣味性,牢牢吸引学生的注意力,让实验课程变得生动有趣,寓教于乐,深受学生的喜爱。
3. 细胞微管蛋白的免疫荧光染色及观察
免疫荧光技术是将免疫学方法与荧光标记技术结合起来研究特异蛋白抗原在细胞内分布的方法。微管是真核细胞中普遍存在的结构,是由α、β微管蛋白异二聚体和少量微管结合蛋白聚合而成的中空管状纤维。细胞微管蛋白经过免疫荧光技术染色可在荧光显微镜下显示出胞质内伸展的微管网络。由于免疫荧光技术的连续性,对实验课的开展极具挑战性,通过多次探索和课程改革,将这一重要的研究方法带入实验教学中。在细胞生物学实验中,通过前期的学习,已经熟练掌握细胞培养、细胞传代等基础操作,开展免疫荧光技术检测细胞内β-actin的定位及细胞核染色,通过荧光显微镜对染色细胞进行观察,让学生在学习基础操作的同时,将抽象的实验内容具体形象化,加深学生对实验内容的理解,进一步提高综合素质。

用户登录
还没有账号?
立即注册